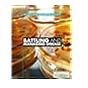

An introductory study guide to public health and epidemiology / Nigel Unwin, Susan Carr, and Joyce Leeson ; with Tanja Pless-Mulloli. 6
By: Unwin, Nigel, 4 0 16 [, ] | [, ] |
Contributor(s): 5 6 [] |
Language: Unknown language code Summary language: Unknown language code Original language: Unknown language code Series: ; Buckingham ;;Philadelphia : Open University Press, [1997];copyright 199746Edition: Description: 25 cm. vii, 152 pages : illustrationsContent type: text Media type: 2 Carrier type: volumeISBN: 335157858ISSN: 2Other title: Public health and epidemiology. 6 []Uniform titles: | | Subject(s): -- 2 -- 0 -- -- | -- 2 -- 0 -- 6 -- | 2 0 -- | -- -- 20 -- | | -- -- Outlines, syllabi, etc.;Outlines, syllabi, etc.;Outlines, syllabi, etc.;examination questions.;nurses' instruction.;examination questions.;nurses' instruction. Public health;Public health nursing;Epidemiology;Test-taking skills.;Public Health;Public Health;Epidemiology;Epidemiology -- -- 20 -- | -- -- -- 20 -- --Genre/Form: -- 2 -- Additional physical formats: DDC classification: | LOC classification: | Ref RA440 | .U59 19972Other classification:| Item type | Current location | Home library | Collection | Call number | Status | Date due | Barcode | Item holds |
|---|---|---|---|---|---|---|---|---|
| Book | PLM | PLM Health Sciences Library | Health Sciences-Reserved | Ref RA440 .U59 1997 (Browse shelf) | Available | H28265 |
Browsing PLM Shelves , Shelving location: Health Sciences Library , Collection code: Health Sciences-Reserved Close shelf browser
|

|

|
No cover image available |

|
No cover image available |

|
||
| Ref RA431 .B388 2011 Battling and managing disease / | Ref RA440 .C666 2003 Community health education methods : a practical guide / | Ref RA440 .C666 2009 Community health education methods : a practical guide / | Ref RA440 .U59 1997 An introductory study guide to public health and epidemiology / | Ref RA441 .L48 2007 Case studies in global health : millions saved / | Ref RA445 .T87 2009 Public health : what it is and how it works / | Ref RA485 .C666 2008 Community public health in policy and practice : a sourcebook / |
56
Includes bibliographical references (p. 146-148) and index.
5
5

There are no comments for this item.